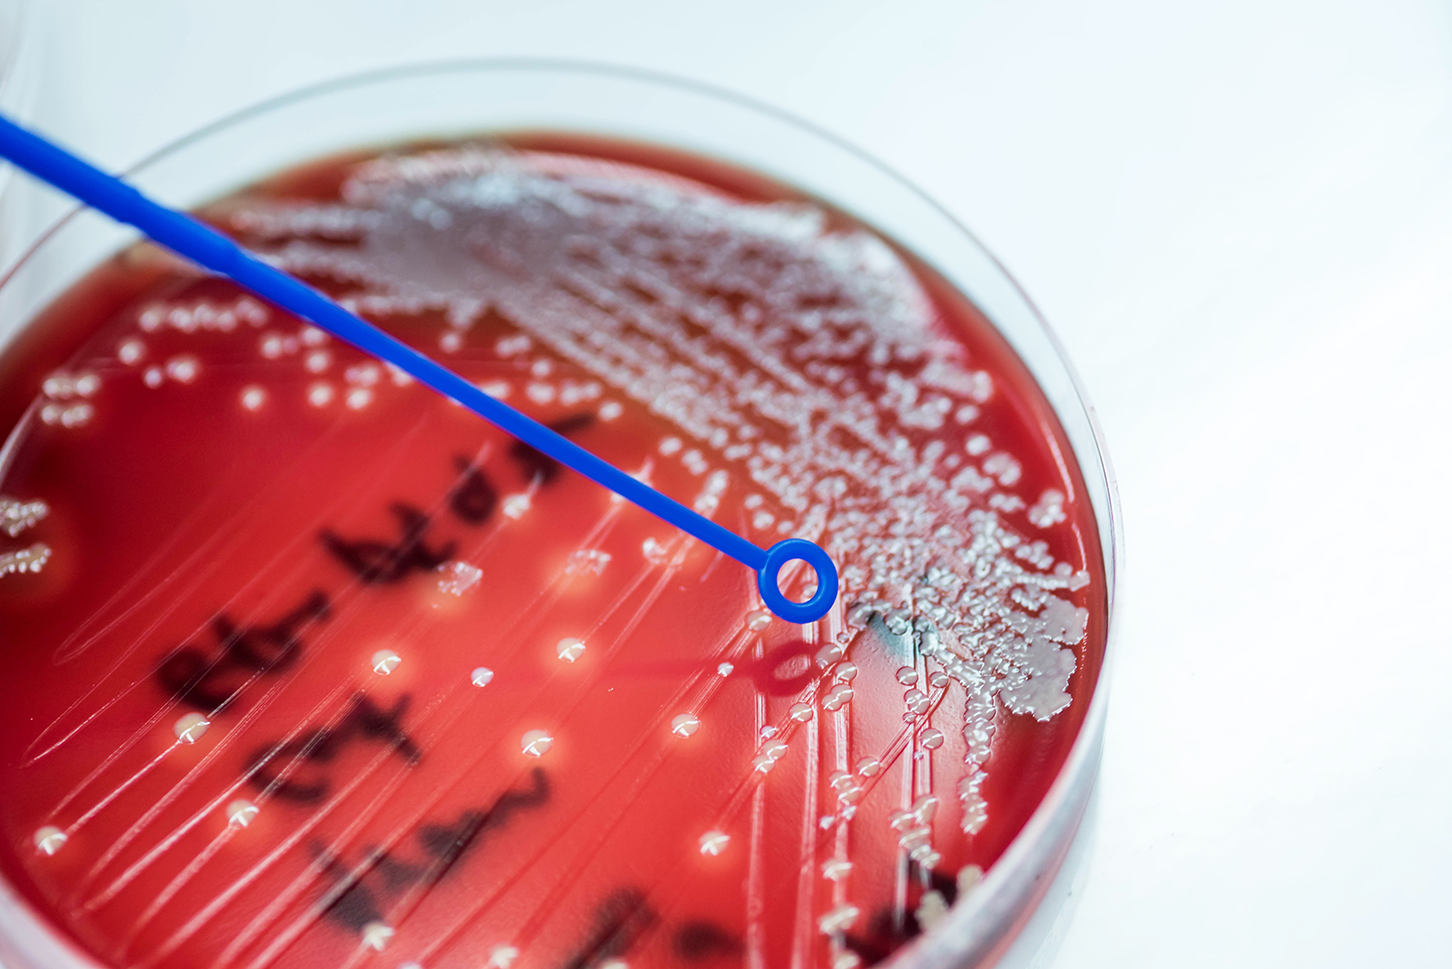
Coagulase-negative Staphylococcus (CoNS), a common skin commensal organism found in a blood culture bottle.

Preventing Adult Blood Culture Contamination: A Quality Tool for Clinical Laboratory Professionals
Protect Patients during the Diagnostic Process by Monitoring Adult Blood Culture Contamination (BCC) Rates
Download a printable version of this tool — PDF.

An antibiotic stewardship team including laboratory professionals discussing ways to improve blood culture collection in their hospital.
Laboratory analysis of blood cultures is vital to the accurate and timely diagnosis of bloodstream infections. However, the reliability of your testing depends on clinical compliance with collection procedures that limit the risk of inconclusive or incorrect results. False negative blood culture results due to inadequate volumes of blood can result in misdiagnosis, delay therapy, and put patients at heightened risk of morbidity and mortality from bacteremia. Likewise, the presence of commonly occurring bacteria or fungi on human skin (i.e., commensal organisms) can increase the risk of false positives, compromising care by leading to unnecessary antibiotic therapy and prolonged hospitalization.
In December 2022, a Centers for Medicare & Medicaid Services (CMS) consensus-based organization endorsed a CDC proposal for a new patient safety measure to address these concerns (see Quality Measures | CMS for more on this topic). CDC developed this quality measure to promote blood culture best practices and improve the laboratory diagnosis of bloodstream infection.
The Clinical Laboratory Improvement Amendments of 1988 (CLIA) state that laboratories must monitor, assess, and when indicated, correct problems identified in their preanalytic systems. Using the methods provided in this quality tool to calculate the BCC and single-set rates will help meet this standard and ensure optimal blood culture collection. In addition, this quality measure incorporates best practices on blood culture collection from the Clinical & Laboratory Standards Institute (CLSI) and the Infectious Disease Society of America (IDSA). These best practices are already in place at many laboratories across the nation and have shown to improve the laboratory diagnosis of bacteremia, significantly reduce incidence of BCC, and limit unnecessary antibiotic therapy. CDC strongly encourages you to adopt these practices into your laboratory’s standard operating procedures (SOPs), to integrate this measure into your quality management system, and to work with infection control and antibiotic stewardship programs to educate and train clinical staff on their use.
"Laboratory Requirements," Code of Federal Regulations, Title 42 (2023): Chapter IV, Part 493
The laboratory must establish and follow written policies and procedures for an ongoing mechanism to monitor, assess, and when indicated, correct problems identified in the preanalytic systems specified at §§ 493.1241 through 493.1242.
Collecting Adult Blood Culture Sets
A blood culture set from an adult patient should consist of 20–30 mL of blood collected through venipuncture. This may require more than two bottles, depending on the blood culture system and the institutional policy.
Collect Multiple Sets to Achieve the Optimal Volume

Example of some blood culture collection supplies.
The volume of blood collected is critically important to the laboratory diagnosis of bloodstream infection, which generally requires two or more sets to achieve. In addition, two sets are required to determine whether the presence of a commensal organism can be classified as a possible contaminant.
To achieve an optimal volume, the blood culture collection standard of practice is to collect two to four blood culture sets from adult patients with a suspected blood stream infection in the evaluation of each septic episode (i.e., 24 hours). Your hospital or clinical setting should instruct healthcare staff to collect at least two blood culture sets (total volume of 40–60 mL) within a 24-hour period by peripheral venipuncture prior to antibiotic administration, if possible.

Laboratory professionals reviewing a blood culture collection SOP on a dedicated electronic device.
“Laboratory Requirements,” Code of Federal Regulations, Title 42 (2023): Chapter IV, Part 493
Subpart K – Quality System for Non-Waived Testing – § 493.1200 Introduction
Each laboratory that performs nonwaived testing must establish and maintain written policies and procedures that implement and monitor a quality system for all phases of the total testing process (that is, preanalytic, analytic, and postanalytic) as well as general laboratory systems.
"Laboratory Requirements," Code of Federal Regulations, Title 42 (2023): Chapter IV, Part 493
Subpart K – Quality System for Non-Waived Testing – § 493.1232 Standard: Specimen identification and integrity.
The laboratory must establish and follow written policies and procedures that ensure positive identification and optimum integrity of a patient's specimen from the time of collection or receipt of the specimen through completion of testing and reporting of results.
CDC encourages you to use the following model to establish an effective blood culture collection SOP in your clinical setting:
- Use at least two unique patient – specific identifier(s) to identify the patient (it is good practice to use more than one unique identifier, e.g., patient’s name and date of birth).
- Disinfect the venipuncture site with an appropriate skin disinfectant product containing alcohol.
- Using alcohol to remove the normally occurring skin oils allows water-based preparations to reach and decontaminate the skin surface.
- Disinfect the rubber septum on the blood culture bottles or evacuated tube(s) with 70% isopropyl alcohol.
- Collect blood before antimicrobial therapy if possible.
- Collect the first blood culture set, usually consisting of one aerobic and one anaerobic bottle.
- Collect 10 mL of blood in each bottle for a target total blood volume of 20 mL in each set (40 mL when collecting two blood culture sets).
- The volume of blood collected, not timing, is most critical.
- Measure and document the volume of blood collected in each bottle.
- Document the body (anatomic site) from which the blood culture was collected (e.g., left antecubital, right subclavian, left hand).
- Document the collection method (e.g., venipuncture or from a central line or arterial line).
- Document the staff person who drew the blood cultures.
- Document the location in the facility where the blood cultures were drawn (e.g., Emergency Department, Intensive Care Unit, etc.).
- Repeat steps (1–11) after the first set to collect the second blood culture set using one aerobic and one anaerobic bottle.
- The upper extremity is the preferred venipuncture site, using the right and left antecubital fossa, if possible.
- Transport the blood culture sets immediately to the laboratory for processing.
“Laboratory Requirements,” Code of Federal Regulations, Title 42 (2023): Chapter IV, Part 493
Subpart K – Quality System for Non-Waived Testing – §493.1242 Standard: Specimen submission, handling, and referral.
(a) The laboratory must establish and follow written policies and procedures for each of the following, if applicable:
(1) Patient preparation.
(2) Specimen collection.
(3) Specimen labeling, including patient name or unique patient identifier and, when appropriate,
specimen source.
(4) Specimen storage and preservation.
(5) Conditions for specimen transportation.
(6) Specimen processing.
(7) Specimen acceptability and rejection.
(8) Specimen referral.
(b) The laboratory must document the date and time it receives a specimen.
(c) The laboratory must refer a specimen for testing only to a CLIA-certified laboratory or a laboratory meeting equivalent requirements as determined by CMS.
(d) If the laboratory accepts a referral specimen, written instructions must be available to the laboratory’s clients and must include, as appropriate, the information specified in paragraphs (a)(1) through (a)(7) of this section.
Primary Measure — Blood Culture Contamination Rate
The microbiology laboratory determines a probable contaminated blood culture by the identification of a skin commensal organism in one set out of multiple sets collected in a 24-hour period. Understanding how often this occurs at the institutional level is critically important to maintaining quality practices at your facility and improving patient care. The primary measure (i.e., BCC rate) is a way for you to calculate the relative incidence of contaminated blood cultures at your facility so that you may monitor compliance with best practices and determine if mitigation strategies are needed. CDC encourages laboratories to evaluate their BCC rate at least monthly.
This section provides a method to help you determine which specimens are eligible for inclusion when calculating the BCC rate and understand how to classify and report potential contaminants.
Primary Measure Eligibility Criteria

Representation of two blood culture sets with an aerobic and anaerobic bottle in each set, showing 10 mL of blood collected in each bottle for a total volume of 40 mL.
If your laboratory identifies the presence of a skin commensal organism in a blood culture set, you should only include that set in the primary measure calculation if all the following criteria are met:
- Patient is at least 18 years old.
- Patient may be present in any hospital department such as the intensive care unit (ICU), emergency department (ED), inpatient floors, step-down units.
- Institutions may choose to include outpatients in their analysis
- At least two blood culture sets are collected in a 24-hour period.
Classify Organisms
Laboratories can classify microorganisms using CDC’s National Healthcare Safety Network (NHSN). The NHSN provides a list of bacterial skin commensal organisms categorized by both genus and genus and species. You can use this list to identify skin commensal organisms by name and corresponding SNOMED code.
- Visit this website: BSI | PSC | NHSN | CDC.
- Look on the right side of the page in the “Supporting Materials” module for the NHSN organism list.
Coagulase-negative Staphylococcus (CoNS), a common skin commensal organism found in a blood culture bottle.
If your laboratory identifies the presence of a skin commensal organism in a set that meets the primary measure eligibility criteria, you could report the test result to the clinician as follows: “Single-set positive out of two sets [or more, if this is the laboratory policy] may indicate the presence of possible skin contaminant, clinical correlation required. Please call the laboratory if further work–up is needed.” This comment alerts the clinician of a probable contaminant event and allows them to evaluate the clinical situation and determine next steps, if needed.
Calculate the Overall BCC Rate in Your Clinical Setting
To calculate the BCC rate, divide the total number of eligible blood culture sets with growth of a skin commensal organism in only one of the sets collected within a 24-hour period by the total number of eligible blood culture sets collected during the monthly evaluation period, multiplied by one hundred.
- Denominator: Use the Laboratory Information System (LIS) to find all blood culture order codes within a specified timeframe (usually monthly) to identify the total number of blood culture sets collected
- Numerator: Use the LIS to find all probable contaminants by identifying all probable skin commensal organism result codes within a specified timeframe (usually monthly)
- Divide the total number of blood culture sets with growth of skin commensals without the same organism in other sets collected within 24 hours by the total number of eligible blood culture sets collected.
Total number of blood culture sets with growth of skin commensals
without the same organism in other sets collected within 24 hours
________________________________________________________________________ x 100Total number of all eligible blood culture sets collected*
* Eligible Blood Culture Sets = At least two blood culture sets collected from an adult patient within a 24-hour period
Sub-Measure — Single-Set Culture Rate

Representation of a single-set collection with one aerobic and one anaerobic bottle, showing 10 mL of blood collected in each bottle for a total volume of 20 mL.
When healthcare staff collect only one blood culture set from a patient in a 24-hour period, the laboratory will not have an adequate volume of blood to reliably diagnose bacteremia or identify a possible contaminated blood culture. These single-set blood cultures do not meet the primary measure eligibility criteria and should not be included when calculating BCC rate, but they must not be ignored.
The sub-measure is a way to calculate the relative incidence of single-set blood culture collection at your facility over a given period. Understanding how often healthcare staff collect an inadequate volume of blood for diagnostic purposes is critically important to maintaining quality practices at your facility and improving patient care. CDC encourages you to calculate your institutional single-set blood culture rate at least monthly in conjunction with the BCC rate.
This section provides a method to help you determine which specimens are eligible for inclusion in the sub-measure, report single-set blood cultures to the clinician, and calculate your institutional single-set blood culture rate.
Sub–Measure Eligibility Criteria
Include a blood culture set in the sub-measure calculation if it meets the following criteria:
- Patient is at least 18 years old.
- Patient may be present in any hospital department such as ICU, ED, inpatient floors, step- down units. (No outpatients)
- Institutions may choose to include outpatients in their analysis
- Only one blood culture set is collected in a 24-hour period.
If a single-set is received a comment could be added to the test result as follows: “Single-set blood culture received; at least two sets needed to achieve the optimal volume (40-60 mL) for diagnosis of bacteremia, or false negatives may occur. Recommend drawing additional blood culture sets if clinically indicated.” This comment alerts the clinician that an inadequate volume of blood was received in the laboratory for testing and allows them to evaluate the clinical situation and determine the next steps, if needed.
Calculate the Single–Set Blood Culture Rate
To calculate the single-set blood culture rate, divide the total number of sub-measure eligible blood culture sets by the total number of blood culture sets collected during the monthly evaluation period, multiplied by one hundred.
- Denominator: Using data from the LIS, identify all blood cultures collected by identifying all blood culture order codes within a specified timeframe (usually monthly)
- Numerator: Using data from the LIS, identify all single-set blood cultures by identifying all events when only one bottle or one blood culture set (usually 1 aerobic and 1 anaerobic bottle) was collected in a specified timeframe (usually monthly)
- Calculate the single-set rate by dividing the number of single-set blood cultures either one bottle or one blood culture set (usually 1 aerobic and 1 anaerobic bottle) by the total number of blood culture sets collected.
Number of single set blood cultures without another set
Collected within 24 hours
_______________________________________________________________________________ x 100
Total number of blood culture sets collected*
* Total number of blood culture sets = Total number of two or more sets plus the total number of single–sets either one bottle or one blood culture set.
Reporting and Taking Action
Evaluating the BCC rate in conjunction with the single-set rate provides vital insight into the blood culture collection practices in the clinical setting. Gaps revealed during the evaluation process indicate the need to investigate and determine mitigation strategies to improve compliance with best practices and standardization of the process. CDC’s goal in developing and promoting this quality measure is to optimize blood culture collection and laboratory diagnostics for all patients, no matter when or where the blood culture is collected.
Reporting and Following Up on BCC and Single-Set Collection Rates
Clinical laboratories could calculate the BCC and single-set rates as quality monitors at the beginning of the month. This will allow you to evaluate your clinical staff’s compliance with blood culture collection best practices and determine the need for, or monitor the effectiveness of, mitigation strategies.
Laboratory staff could meet with their facility’s antibiotic stewardship and infection prevention personnel to educate them about the BCC and single-set quality measures. This provides an opportunity to discuss how tracking these events can be used to monitor and evaluate practices to improve processes. You can also target improvement efforts by sharing reports showing rates stratified by patient care locations and collection staff (e.g., nursing or phlebotomy teams.)
Some mitigation strategies that could be implemented when working with your antibiotic stewardship team include
- Diagnostic stewardship
- Proper skin antisepsis
- Blood culture bottle disinfection
- Blood culture collection site
- Hand hygiene
- Phlebotomy teams and education on proper technique
- Surveillance and feedback
- Diversion devices

A healthy patient discharged from the hospital.
By generating, evaluating, and acting on the BCC and single-set rates, you can reduce false positive and false negative blood culture results. Clinical laboratories may use this data to address patient safety opportunities by improving the quality of the blood culture testing process.
References
- A Comprehensive Update on the Problem of Blood Culture Contamination and a Discussion of Methods for Addressing the Problem
- Standards and Certification: Laboratory Requirements, 42 CFR, Chapter IV, Part 493
- A Guide to Utilization of the Microbiology Laboratory for Diagnosis of Infectious Diseases
- Clinical and Laboratory Standards Institute (CLSI) M47 ED2-2021 Principles and Procedures for Blood Cultures 2nd Edition
- Core Elements of Hospital Antibiotic Stewardship Programs | Antibiotic Use | CDC
Contact Information
If you have questions about this tool, email DLSInquiries@cdc.gov.
Download a printable version of this web page: PDF.